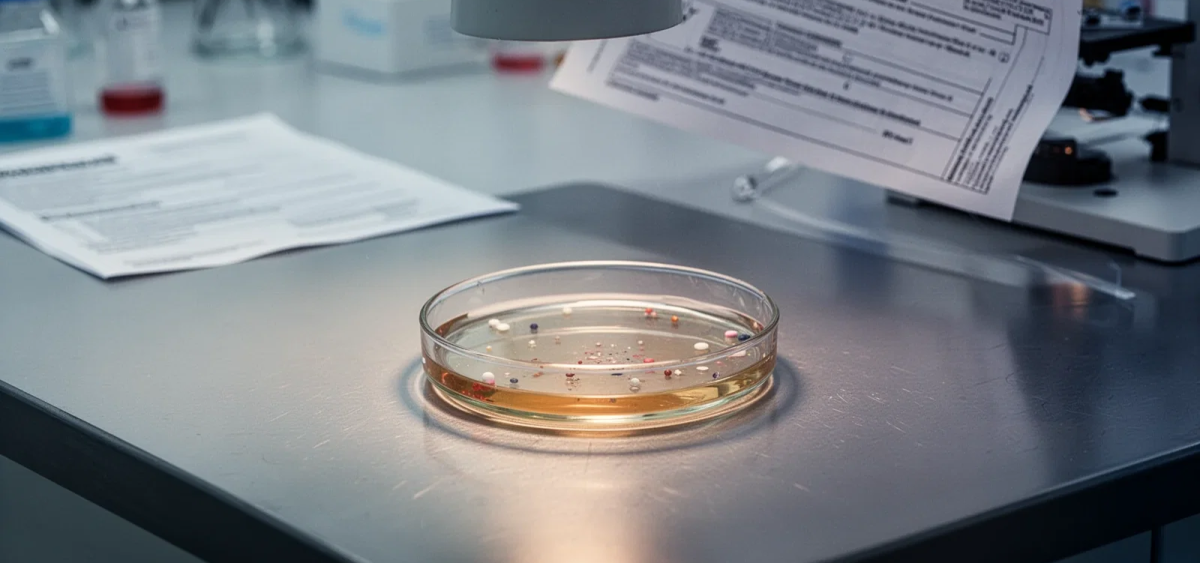
Beitragsbild zu Newron SpA Aktie: Aktuelle Wirtschaftsleistung

Newron SpA Aktie: Aktuelle Wirtschaftsleistung
Nach der Veröffentlichung der Jahreszahlen 2025 haben vier Analysten ihre Schätzungen für Newron Pharmaceuticals deutlich nach unten korrigiert. Die Umsatzprognose für 2026 wurde von zuvor 29 Millionen Euro auf nur noch 13 Millionen Euro halbiert — ein Rückgang von rund 32 Prozent gegenüber den vergangenen zwölf Monaten. Gleichzeitig soll der Verlust je Aktie von 0,50 Euro auf 1,53 Euro steigen, ein Anstieg von 140 Prozent.
Warum die Zahlen täuschen können
Der Einbruch bei den Erlösen klingt alarmierend, hat aber einen konkreten Grund: 2024 profitierte Newron von einer einmaligen Vorauszahlung aus dem Lizenzvertrag mit EA Pharma (Eisai Group), die den Jahresüberschuss auf 15,8 Millionen Euro hob. Ohne diesen Sondereffekt fiel der Nettoverlust 2025 auf 13,2 Millionen Euro — eine strukturelle Verschiebung, keine operative Verschlechterung.
Bemerkenswert ist, dass das Kursziel der Analysten mit durchschnittlich 53,91 Euro nahezu unverändert blieb. Das deutet darauf hin, dass die Konsenserwartungen an das langfristige Potenzial des Unternehmens weitgehend intakt sind, auch wenn die kurzfristigen Ergebnisse unter Druck stehen.
Finanzierung gesichert, Datenpunkt rückt näher
Sollten Anleger sofort verkaufen? Oder lohnt sich doch der Einstieg bei Newron SpA?
Trotz des erweiterten Verlustes verbesserte sich die Liquidität deutlich: Die Barmittel stiegen von 9,8 Millionen Euro zu Jahresbeginn 2025 auf 28,9 Millionen Euro zum Jahresende. Zusammen mit den 15 Millionen Euro aus der Kapitalerhöhung im Februar 2026 und weiteren 11 Millionen Euro, die noch bis Ende 2026 aus einem Finanzierungsvertrag erwartet werden, soll die Finanzierung der laufenden Programme bis weit ins Jahr 2027 gesichert sein. Zusätzlich einigte sich Newron im März 2026 mit der Europäischen Investitionsbank auf eine Verlängerung der Fälligkeit bestehender Kreditlinien bis Juni 2028.
Der eigentliche Treiber der Aktie bleibt das ENIGMA-TRS-Programm. Die pivotale Phase-III-Studie mit Evenamide — eine internationale, doppelblinde, placebokontrollierte Untersuchung an mindestens 600 Patienten — läuft seit August 2025. Erste Ergebnisse werden noch in diesem Jahr erwartet. Parallel startete EA Pharma im Januar 2026 eine eigene Phase-III-Studie in Japan, was die globale Reichweite des Programms erweitert.
Die Bandbreite der Analystenkursziele — von 40,32 Euro auf der pessimistischen bis 79,99 Euro auf der optimistischen Seite — spiegelt die binäre Natur dieser Situation wider. Alles hängt an den Daten, die voraussichtlich im vierten Quartal 2026 vorliegen werden.
Newron SpA-Aktie: Kaufen oder verkaufen?! Neue Newron SpA-Analyse vom 31. März liefert die Antwort:
Die neusten Newron SpA-Zahlen sprechen eine klare Sprache: Dringender Handlungsbedarf für Newron SpA-Aktionäre. Lohnt sich ein Einstieg oder sollten Sie lieber verkaufen? In der aktuellen Gratis-Analyse vom 31. März erfahren Sie was jetzt zu tun ist.
Newron SpA: Kaufen oder verkaufen? Hier weiterlesen...













